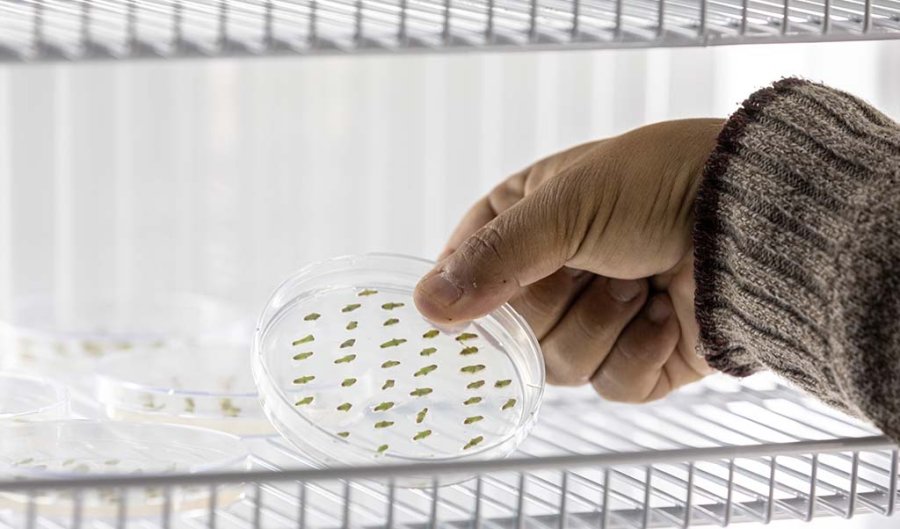

Se trata de especies mejoradas de semillas nativas, que son fuente de forraje para el ganado y mejoran el suelo. Productores ganaderos pueden acceder a ellas gracias a la articulación de capacidades de la UNL y la empresa argentina Peman.
La Universidad Nacional del Litoral (UNL) y la empresa Oscar Peman y Asociados SA llevan adelante una línea de trabajo conjunto, que data desde el año 2013, basada en la documentación, conservación y valorización de la flora nativa. Desde los inicios de la ganadería en el país, se reconoce el valor forrajero de algunas especies. Su siembra permite el mejoramiento de la productividad y calidad del pastizal natural. Sin embargo, muy pocas especies han sido estudiadas con fines agronómicos y menos aún domesticadas e introducidas a cultivo. La UNL, a través del grupo de investigadores de la Facultad de Ciencias Agrarias dedicado al estudio de especies nativas y naturalizadas con interés agronómico (Programa Institucional orientado a la Documentación, Conservación y Valoración de la Flora Nativa -PRODOCOVA-), cuenta con valiosos materiales mejorados de especies nativas, algunos de los cuales han sido inscriptos ante el Instituto Nacional de Semillas (INASE).
A partir de la firma de acuerdos de colaboración para la investigación y el desarrollo, la UNL y la empresa cordobesa Oscar Peman y Asociados SA., articularon sus capacidades con el propósito de transferir tecnología para la producción de semillas forrajeras de los cultivares de propiedad de la UNL. Cabe destacar que en Argentina dicho proyecto, pionero en su tipo, tiene por objetivo el desarrollo de un paquete tecnológico para la producción de semillas de seis cultivares de leguminosas subtropicales, que son resultado de un trabajo de mejoramiento genético de especies leguminosas nativas. Éstas presentan ventajas significativas, cubriendo el nicho existente de demanda de una leguminosa que mejora la eficiencia de producción en zonas marginales. Esto permitió contar con un producto nacional y con alto valor agregado, desarrollado a partir de la interacción de los resultados de la investigación generados en una institución de I+D, junto a la experiencia de una empresa líder en el sector.
Licencias para la comercialización
Como resultado de un extenso proceso de trabajo del equipo de investigación de la UNL, se han inscripto seis variedades de semilla de las cuales, hasta el momento, tres fueron licenciadas a la empresa Peman, con la que confluyen varios años de trabajo. La proyección a futuro es hacer lo mismo con las demás variedades.
Cabe señalar que las variedades de semillas tienen la particularidad de ser inscriptas en el INASE y lograr un derecho especial, que no es una patente industrial, tal y como se la conoce habitualmente. En este caso, la UNL tiene el derecho de esas variedades por 20 años. A partir de allí, la UNL licencia a empresas de semillas con el propósito de que se inserten al mercado para la venta, dado que la universidad no es un organismo semillero, o de comercialización de semillas.
Entre los años 2015 y 2016, la UNL firmó un convenio con la empresa que abarcó la licencia de las primeras dos variedades de semillas. Y en el pasado 2020, se hizo lo respectivo con la tercera variedad. Con ello, se comenzó un trabajo articulado de multiplicación de semillas, de cara a la comercialización en el mercado.
“Las semillas que están licenciadas son variedades de melilotus alba y una variedad de macroptilium lathyroides, dos especies forrajeras. La particularidad que presentan estas especies, primero, es que se trata de especies de leguminosas. Dentro de las variedades aptas para forraje para los animales, hay dos grandes grupos: las gramiñas y las leguminosas. Para la zona del centro norte de Argentina, las leguminosas son las menos trabajadas, las que menos hay”, explicó Juan Marcelo Zabala, docente investigador de la UNL y director científico tecnológico del proyecto. Por otro lado, algunas de ellas, como la recientemente licenciada macroptilium lathyroides, es una especie nativa, y el primer cultivar que se inscribe de esta especie. Es una variedad forrajera nativa que ha sido valorada mucho antes en otros países (por ejemplo, en Australia) y que, en tanto planta nativa, han venido a América a buscarla. Esa es la cuestión de por qué nosotros empezamos a trabajar”, agregó Zabala.
La empresa Peman, actualmente cuenta con volumen para la venta. “Nosotros les dimos la semilla y la empresa asumió el desafío de reproducir. Esto requirió el desarrollo de una tecnología para producir esas semillas, sobre todo la nativa, porque el melilotus alba es una especie conocida, pero es muy poco trabajada, hay muy pocos cultivares y variedades. Por ello, desarrollamos dos variedades para el centro norte de Argentina”, destacó el director científico tecnológico del proyecto.
Por su parte, Rosalba Peman, integrante titular de la empresa compartió la experiencia de articulación con la UNL: “fue muy buena, ya que se presentó un desafío técnico productivo para la ganadería, que era tratar de encontrar especies leguminosas que pudieran utilizarse en pastoreo, junto con las gramíneas, ya que a nivel país hay un desarrollo grande de gramíneas forrajeras para la zona del Noroeste argentino (NOA) y el Nordeste argentino (NEA), pero había un déficit en pasturas leguminosas que son una de las bases de la dieta animal. La Universidad, a partir de la cátedra de Marcelo Zabala, había desarrollado algunas leguminosas provisorias y las había inscripto como cultivares. La empresa se interesó en ese trabajo; de allí que se generó un vínculo interesante para poder llevar al mercado algunas variedades de esas especies, que pudieran tener un impacto productivo en las pasturas, a nivel nacional”. Tal como lo relata Peman, la posibilidad de licenciar los cultivares brindó una gran oportunidad de crecimiento a la empresa, permitiéndole incorporar una nueva línea de leguminosas subtropicales, ampliando su portfolio de productos. Actualmente estos productos se encuentran disponibles en el mercado nacional.
Articulación universidad empresa que genera valor
A lo largo de este camino emprendido el equipo de investigación de plantas nativas ha accedido a distintas herramientas de financiamiento público que hicieron posible contar con resultados exitosos. En los inicios, accedieron al CAI+D (Curso de Acción para la Investigación y Desarrollo), de la UNL. Posteriormente, un ANR (Aportes No Reembolsables) otorgado por el Fondo Tecnológico Argentino (FONTAR) a la empresa permitió el desarrollo de la tecnología de producción de semillas, ya que las semillas ya estaban generadas.
En este proceso han recibido también acompañamiento por parte del Cetri Litoral de la Secretaría de Vinculación Tecnológica e Innovación en la presentación y administración de proyectos de financiamiento y protección de la propiedad intelectual. Como todo desarrollo de esta naturaleza no se traza en línea recta, sino que ha transitado también por dificultades, marchas, contramarchas y esfuerzos de todas las partes intervinientes. Para tener semillas comercializables a un costo razonable, la empresa ha hecho inversiones en tiempo y en recursos, hasta alcanzar un nivel de producción comercial. “En dos de las tres especies estamos afinados en los niveles de producción, y en la tercera estamos afinando algunos aspectos, para poder contar con mayor volumen”, relató Peman. Asimismo, la inserción en el mercado exige un intenso trabajo de capacitación, difusión, posicionamiento y marketing de la cartera de nuevos productos.
El modelo de cooperación público privado, es para Peman un modelo exitoso “en este caso en particular con la UNL, desde la parte científica y técnica, como desde la estructura de gestión de dicha vinculación, en la que nos facilitaron los procesos de presentación de proyectos para la obtención de financiamiento, fue un trabajo conjunto muy bueno, que recomendaría para que otras Pymes lo hagan. El resultado del modelo de articulación se puede ver con el producto en el mercado, que es el objetivo final de todo el camino. Que un producto desarrollado en la Universidad haya sido licenciado a una empresa y que la empresa haya puesto todo el esfuerzo para poder posicionarlo en el mercado, con un impacto en la producción ganadera del país, pone de manifiesto lo exitoso del modelo”.
El trabajo conjunto también permitió el desarrollo de proyectos sociales que involucraron a pequeños productores de Alejandra (Santa Fe), vinculados con la organización civil APAZ.
Casi tres décadas de trabajo
El Prodocova viene llevando adelante este trabajo de documentación, conservación y preservación de la flora nativa desde el año 2003. Asimismo, cuenta con otra línea de trabajo, que es en especies forestales. “Nuestro trabajo tiene que ver con dos colecciones, el herbario y el banco de semillas, a partir de las cuales colectamos y conservamos material y semillas para empezar a conocerlo y conservarlo”.
Respecto a las especies que aún no se han licenciado, el director científico tecnológico describe que se trata de “macriptilium erytroloma y desmanthus virgatus”, dos especies nativas, de las cuales el equipo de la UNL inscribió los primeros cultivares. “Son nativas de América en términos generales, pero en nuestro país crecen en el centro norte de Argentina. “Desde la UNL Hacemos hincapié en que los cimientos de este trabajo son el herbario, que es el más importante que tiene la provincia de Santa Fe, y que está en la Facultad de Ciencias Agrarias de la UNL, y el Banco de Germoplasma (creado en el 2011) que también es el único en la provincia y es uno de los pocos que a nivel país se dedica a la conservación de semillas de forrajeras nativas. Afirmaría que de las colecciones que tenemos son únicas, no hay otras colecciones de este tipo en forrajeras en el país” sostuvo el investigador.